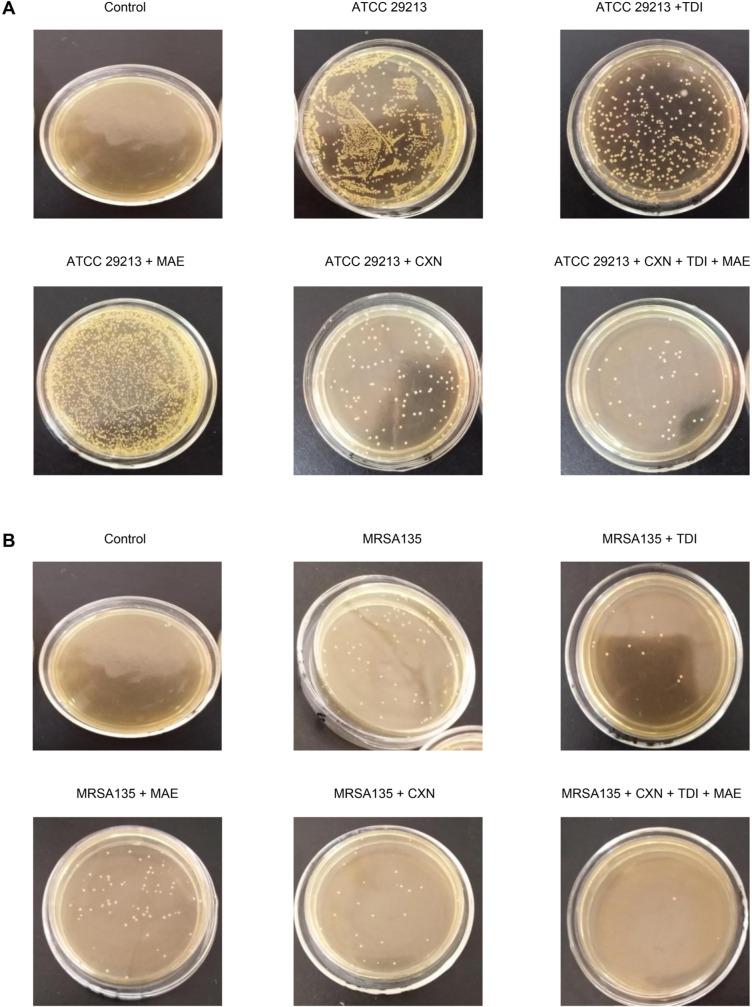
https://cdn.ncbi.nlm.nih.gov/pmc/blobs/cabe/7260704/aab65684a927/pjm-68-4-477-g004.jpg

通过外排泵抑制剂和自溶诱导剂抑制耐药性,增强β-内酰胺类药物的抗菌活性。
Inhibition of Drug Resistance of by Efflux Pump Inhibitor and Autolysis Inducer to Strengthen the Antibacterial Activity of β-lactam Drugs.
机构信息
Key Laboratory for Zoonosis Research, Ministry of Education, Institute of Zoonosis, Department of Infectious Diseases of First Hospital of Jilin University, College of Veterinary Medicine Jilin University , Changchun , China.
Jilin Hepatobiliary Hospital , Changchun , China.
出版信息
Pol J Microbiol. 2019 Dec;68(4):477-491. doi: 10.33073/pjm-2019-047. Epub 2019 Dec 5.
This study explored a potential treatment against methicillin-resistant (MRSA) infections that combines thioridazine (TZ), an efflux pump inhibitor, and miconazole (MCZ), an autolysis inducer, with the anti-microbial drug cloxacillin (CXN). , the combination treatment of TZ and MCZ significantly reduced 4096-fold (Σ (FIC) = 0.1 - 1.25) the MIC value of CXN against . , the combination therapy significantly relieved breast redness and swelling in mice infected with either clinical or standard strains of . Meanwhile, the number of bacteria isolated from the MRSA135-infected mice decreased significantly ( = 0.0427 < 0.05) after the combination therapy when compared to monotherapy. Moreover, the number of bacteria isolated from the mice infected with a reference strain also decreased significantly ( = 0.0191 < 0.05) after the combination therapy when compared to monotherapy. The pathological changes were more significant in the CXN-treated group when compared to mice treated with a combination of three drugs. In addition, we found that combination therapy reduced the release of the bacteria-stimulated cytokines such as IL-6, IFN-γ, and TNF-α. Cytokine assays in serum revealed that CXN alone induced IL-6, IFN-γ, and TNF-α in the mouse groups infected with ATCC 29213 or MRSA135, and the combination of these three drugs significantly reduced IL-6, IFN-γ, and TNF-α concentrations. Also, the levels of TNF-α and IFN-γ in mice treated with a combination of three drugs were significantly lower than in the CXN-treated group. Given the synergistic antibacterial activity of CXN, we concluded that the combination of CXN with TZ, and MCZ could be developed as a novel therapeutic strategy against This study explored a potential treatment against methicillin-resistant (MRSA) infections that combines thioridazine (TZ), an efflux pump inhibitor, and miconazole (MCZ), an autolysis inducer, with the anti-microbial drug cloxacillin (CXN). , the combination treatment of TZ and MCZ significantly reduced 4096-fold (Σ (FIC) = 0.1 – 1.25) the MIC value of CXN against . , the combination therapy significantly relieved breast redness and swelling in mice infected with either clinical or standard strains of . Meanwhile, the number of bacteria isolated from the MRSA135-infected mice decreased significantly ( = 0.0427 < 0.05) after the combination therapy when compared to monotherapy. Moreover, the number of bacteria isolated from the mice infected with a reference strain also decreased significantly ( = 0.0191 < 0.05) after the combination therapy when compared to monotherapy. The pathological changes were more significant in the CXN-treated group when compared to mice treated with a combination of three drugs. In addition, we found that combination therapy reduced the release of the bacteria-stimulated cytokines such as IL-6, IFN-γ, and TNF-α. Cytokine assays in serum revealed that CXN alone induced IL-6, IFN-γ, and TNF-α in the mouse groups infected with ATCC 29213 or MRSA135, and the combination of these three drugs significantly reduced IL-6, IFN-γ, and TNF-α concentrations. Also, the levels of TNF-α and IFN-γ in mice treated with a combination of three drugs were significantly lower than in the CXN-treated group. Given the synergistic antibacterial activity of CXN, we concluded that the combination of CXN with TZ, and MCZ could be developed as a novel therapeutic strategy against
这项研究探索了一种潜在的治疗耐甲氧西林金黄色葡萄球菌(MRSA)感染的方法,该方法将噻嗪(TZ),一种外排泵抑制剂,和咪康唑(MCZ),一种自溶诱导剂,与抗菌药物苯唑西林(CXN)联合使用。研究发现,TZ 和 MCZ 的联合治疗显著降低了 CXN 对 的 MIC 值 4096 倍(Σ(FIC)= 0.1-1.25)。研究发现,联合治疗显著缓解了临床或标准株 感染小鼠的乳房红肿和肿胀。同时,与单独用药相比,联合治疗后从 MRSA135 感染的小鼠中分离的细菌数量显著减少(= 0.0427 < 0.05)。此外,与单独用药相比,联合治疗后从感染参考株的小鼠中分离的细菌数量也显著减少(= 0.0191 < 0.05)。与三药联合治疗组相比,CXN 治疗组的病理变化更为明显。此外,我们发现联合治疗可减少细菌刺激的细胞因子如 IL-6、IFN-γ 和 TNF-α 的释放。血清细胞因子检测显示,CXN 单独感染 ATCC 29213 或 MRSA135 的小鼠组诱导了 IL-6、IFN-γ 和 TNF-α 的释放,而三种药物的联合使用显著降低了 IL-6、IFN-γ 和 TNF-α 的浓度。此外,与 CXN 治疗组相比,三药联合治疗组小鼠的 TNF-α 和 IFN-γ 水平明显降低。鉴于 CXN 的协同抗菌活性,我们得出结论,CXN 与 TZ 和 MCZ 的联合使用可能成为治疗耐甲氧西林金黄色葡萄球菌感染的一种新的治疗策略。